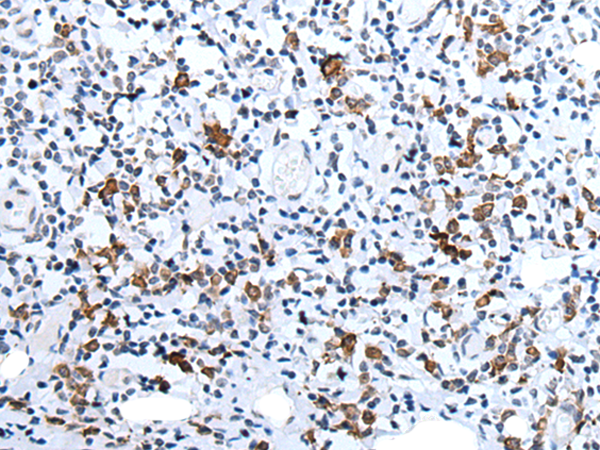

中文名稱: 兔抗HCRT多克隆抗體
別 名: OX; PPOX; NRCLP1
反應(yīng)種屬: Human, Mouse, Rat
標(biāo) 記 物: Unconjugate
Background:
This gene encodes a hypothalamic neuropeptide precursor protein that gives rise to two mature neuropeptides, orexin A and orexin B, by proteolytic processing. Orexin A and orexin B, which bind to orphan G-protein coupled receptors HCRTR1 and HCRTR2, function in the regulation of sleep and arousal. This neuropeptide arrangement may also play a role in feeding behavior, metabolism, and homeostasis.
Applications:
ELISA, IHC
Name of antibody:
HCRT
Immunogen:
Synthetic peptide of human HCRT
Full name:
hypocretin (orexin) neuropeptide precursor
Synonyms:
OX; PPOX; NRCLP1
SwissProt:
O43612
ELISA Recommended dilution:
2000-5000
IHC positive control:
Human colorectal cancer and human tonsil
IHC Recommend dilution:
25-100
技術(shù)規(guī)格

購(gòu)物車
購(gòu)物車 幫助
幫助
 021-54845833/15800441009
021-54845833/15800441009
